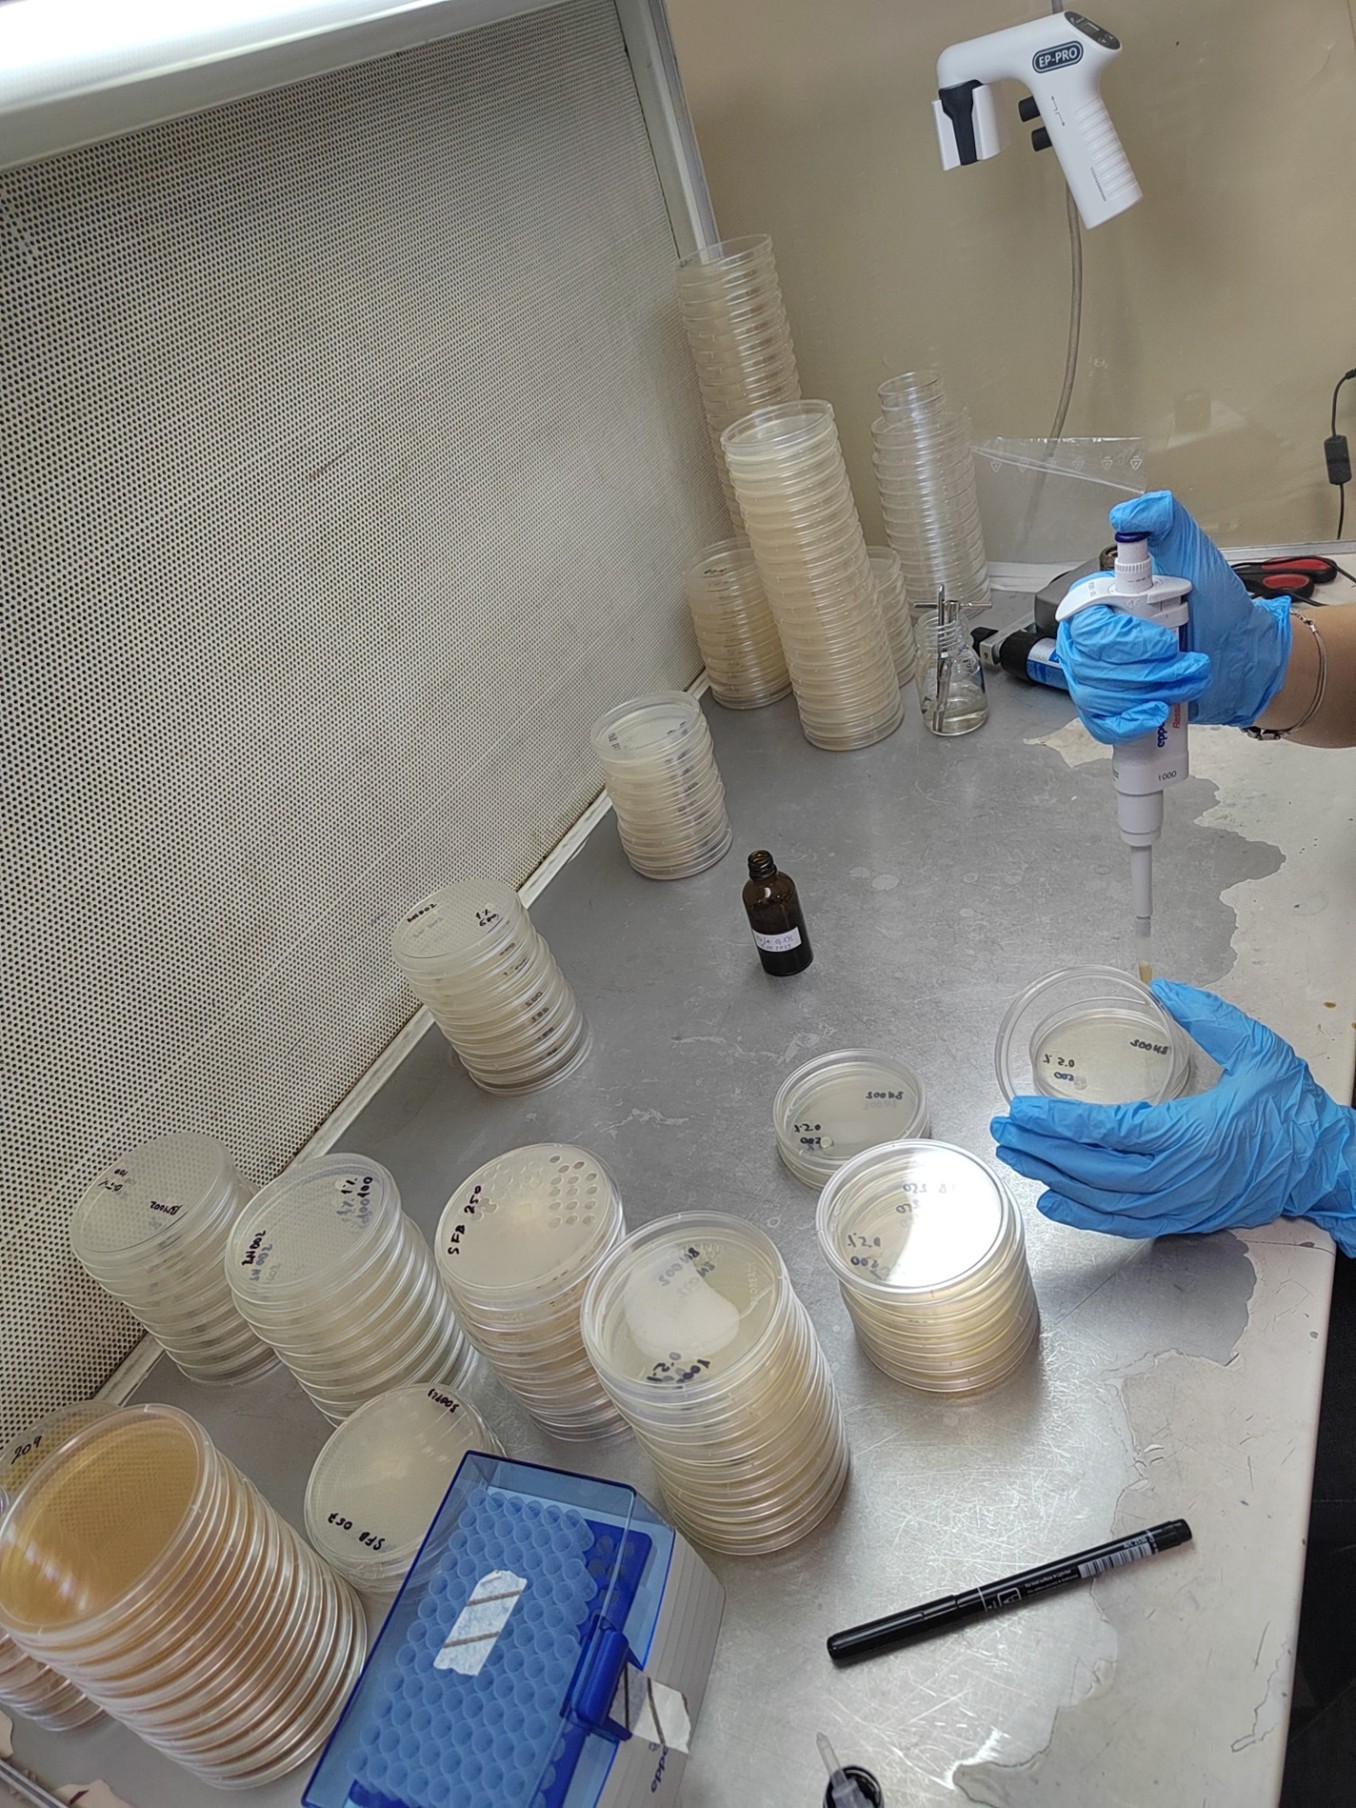
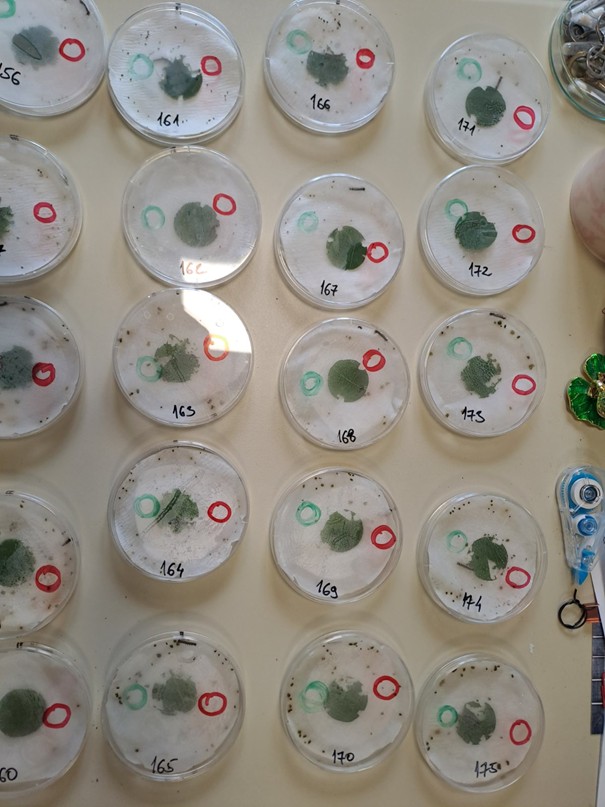

New biopesticides based on nanoencapsulation and slow release of active components for control of gypsy moth (Lymantria dispar) and root pathogens in forests and nurseries
About project
Project title:
New biopesticides based on nanoencapsulation and slow release of active components for control of gypsy moth (Lymantria dispar) and root pathogens in forests and nurseries
Acronym:
PestFreeTree
Financier:
Science Fund of the Republic of Serbia
Budget:
175.000 EUR
Project duration:
2023-2025
Project coordinator:
IMSI
Project partners:
University of Belgrade - Faculty of Forestry, Institute for Medicinal Plant Research "Dr. Josif Pančić"
Project leader for IMSI:
Goran Branković,
principal research fellow
Project website:
Location:
Volgina 15, Belgrade
Keywords:
nanoencapsulation, biopesticide, slow release, forest protection
Research Associate
Telephone:
E-Mail:
Website:
Project description
The gypsy moth (Lymantria dispar) is an invasive pest that weakens and destroys trees by eating most or all of their leaves. Another major threat to forests and crops comes from Phytophthora species, which can cause up to 100% losses in many plants each year, costing billions of dollars worldwide. At the same time, the European Commission has called for a 50% reduction in chemical pesticide use by 2030. This creates a strong need for new, sustainable solutions. PestFreeTree responded to this challenge by developing natural and eco-friendly biopesticides that can be applied in forests, parks, nurseries, and orchards. These solutions protect both: trees and crops from harmful pests, and the environment from soil, water, and air pollution caused by conventional pesticides. Our approach is based on a patented technology originally created for active packaging. By encapsulating essential oils and plant extracts in a biopolymer matrix, we achieved slow release of active substances over 10 days to several weeks. This ensured long-lasting protection, overcoming the problem of volatility and instability of essential oils in open field conditions. The project delivered two innovative biopesticide solutions targeting Lymantria dispar and Phytophthora. In the long run, PestFreeTree will have a positive impact on forestry, agriculture, the biopesticide market, the environment, and society. The project will have a long-term impact on the biopesticides market, forestry, agriculture, environment and society in general.
Results
Project team
- Principle investigator (PI): Goran Branković, principal research fellow, University of Belgrade – Institute for Multidisciplinary Research
- Team members: Zorica Branković, principal research fellow, University of Belgrade – Institute for Multidisciplinary Research
Vanja Tadić, principal research fellow, Institute for Medicinal Plant Research “Dr. Josif Pančić”;
Aleksandar Radojković, principal research fellow, University of Belgrade – Institute for Multidisciplinary Research;
Jovana Ćirković, senior research associate, University of Belgrade – Institute for Multidisciplinary Research;
Sanja Perać, senior research associate, University of Belgrade – Institute for Multidisciplinary Research;
Jelena Jovanović, research associate, University of Belgrade – Institute for Multidisciplinary Research;
Slobodan Milanović, full professor, University of Belgrade – Faculty of Forestry;
Ivan Milenković, associate professor, University of Belgrade – Faculty of Forestry;
Jovan Dobrosavljević, teaching assistant, University of Belgrade – Faculty of Forestry.